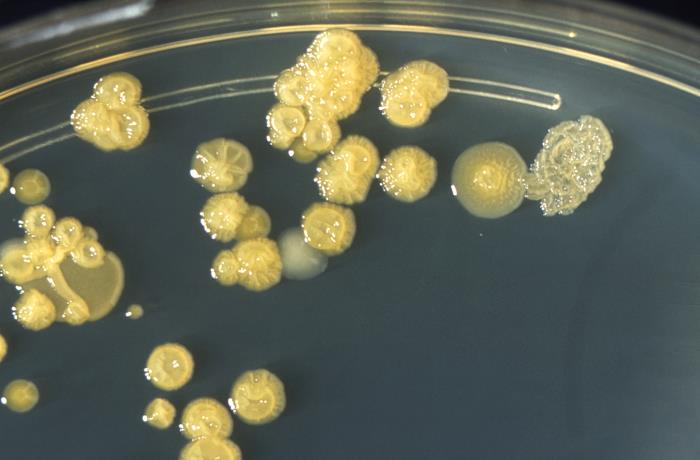

obacter asburiae
Enterobacter asburiae 118 фото
Саидов санкт петербург
Почему летает моль
Где пожар в турции сегодня
Айноске шиндо
Мода 1850 года
Это мой потенциал костюшкин и дава
Полость приложить
Упростите выражения 3а 1 2а 7
Истерика перед сном у ребенка 2 года
Расписание автобусов прокопьевск красный камень